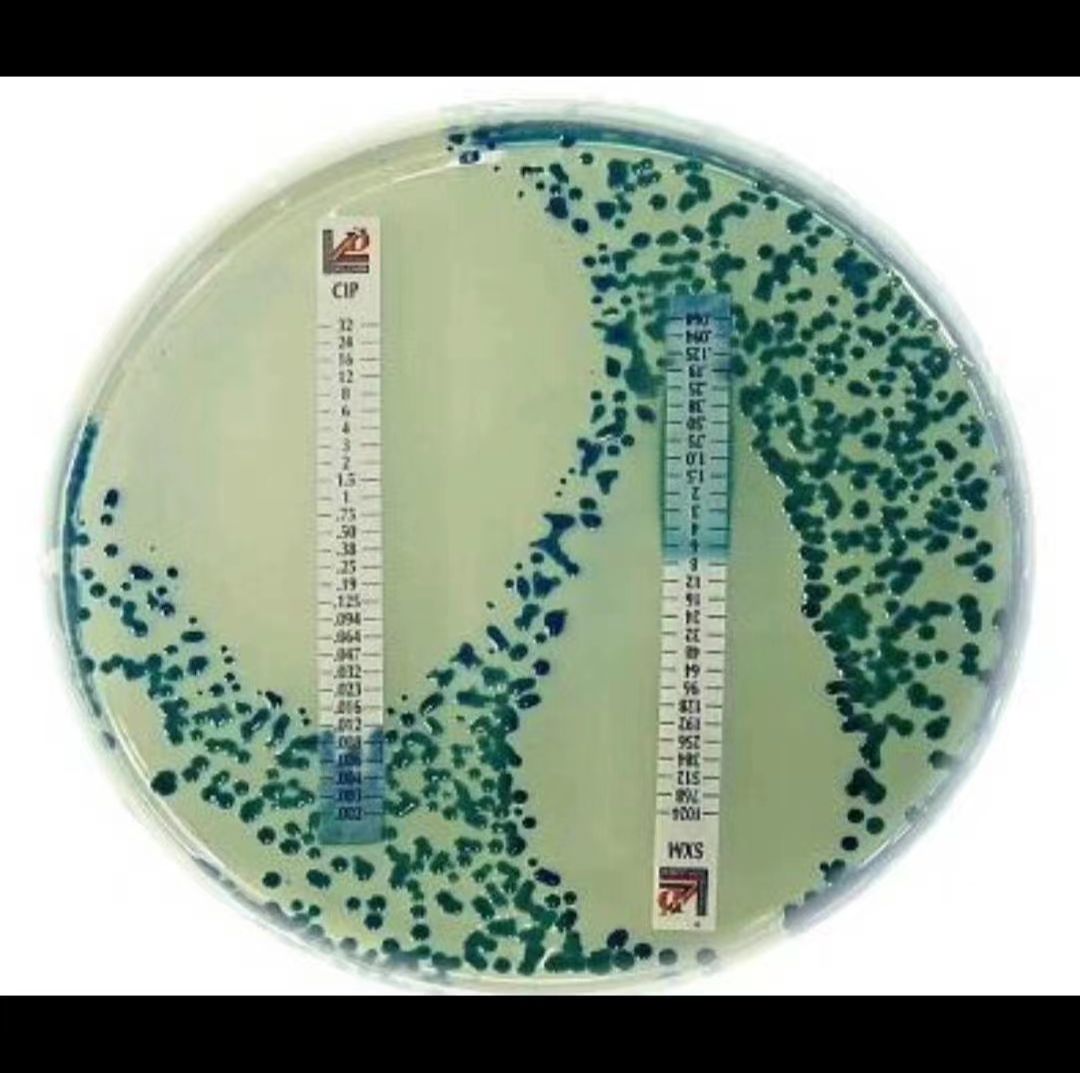
产品封面图

相关产品推荐更多 >
万千商家帮你免费找货
0 人在求购买到急需产品
- 详细信息
- 文献和实验
- 技术资料
- 库存:
大量
- 保质期:
6 个月
- 供应商:
艾研
- 保存条件:
无血清细胞冻存液
- 规格:
T25
风险提示:丁香通仅作为第三方平台,为商家信息发布提供平台空间。用户咨询产品时请注意保护个人信息及财产安全,合理判断,谨慎选购商品,商家和用户对交易行为负责。对于医疗器械类产品,请先查证核实企业经营资质和医疗器械产品注册证情况。
文献和实验小鼠脑神经瘤细胞概述及培养方法! 一、细胞介绍 克隆 Neuro-2A 是由 R.J.Klebe 和 F.H.Ruddle 经 A 株白鼠的自生肿瘤建立。该细胞产生大量微管蛋白,此蛋白在神经细胞中起应答轴浆流动的收缩系统作用。 二、基本信息 平台编号:bio-73109
实验步骤 1. 小鼠用pH值7.4,0.1M PBS彻底穿心灌注。 2. 用剪刀去头。 3. 剥开头骨的软组织。 4. 除去下颌骨。 5. 除去头骨延髓到上颌骨之间的组织。 6. 手术剪刀,取出头骨顶部,顺时针方向切割,开始和结束于右后鼓膜钩。 7. 舀出大脑,维持组织的完整性。 8. 立即将脑组织置于预冷的流式细胞术缓冲液中(1%BSA 1mM的EDTA的 pH值7.4 0.1M PBS,50
实验步骤 为了检测小胶质细胞的吞噬功能,利用凋亡的神经祖细胞作为目标,因为在体外环境下它能最模拟自然条件下小胶质细胞的吞噬目标。 1. 将神经祖细胞(NPC)置于0.1M PBS 2mg/ml木瓜蛋白酶(Worthington)溶液中进行分离,37ºC作用30min。 2. 将分离的NPC 在紫外光下处理15-20min。 注:此步应该在一个很薄的塑料培养皿中进行,厚的塑料(如15或50毫升锥形管)将阻止
技术资料暂无技术资料 索取技术资料